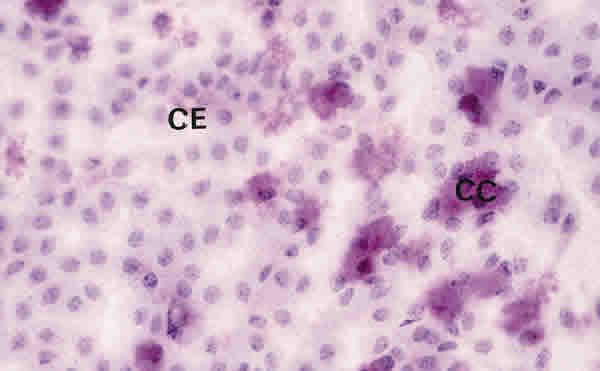

Figura 3
CITOLOGÍA DE IMPRESIÓN EN UN PACIENTE CON QCS-GRADO II. EL NÚMERO DE CÉLULAS CALICIFORMES (CC) ES MENOR QUE EN LA QCS-GRADO I. LAS CÉLULAS EPITELIALES (CE) SON MAYORES Y ESTÁN MODERADAMENTE SEPARADAS. TINCIÓN PAS-HEMATOXILINA. MAGNIFICACIÓN ORIGINAL X40.